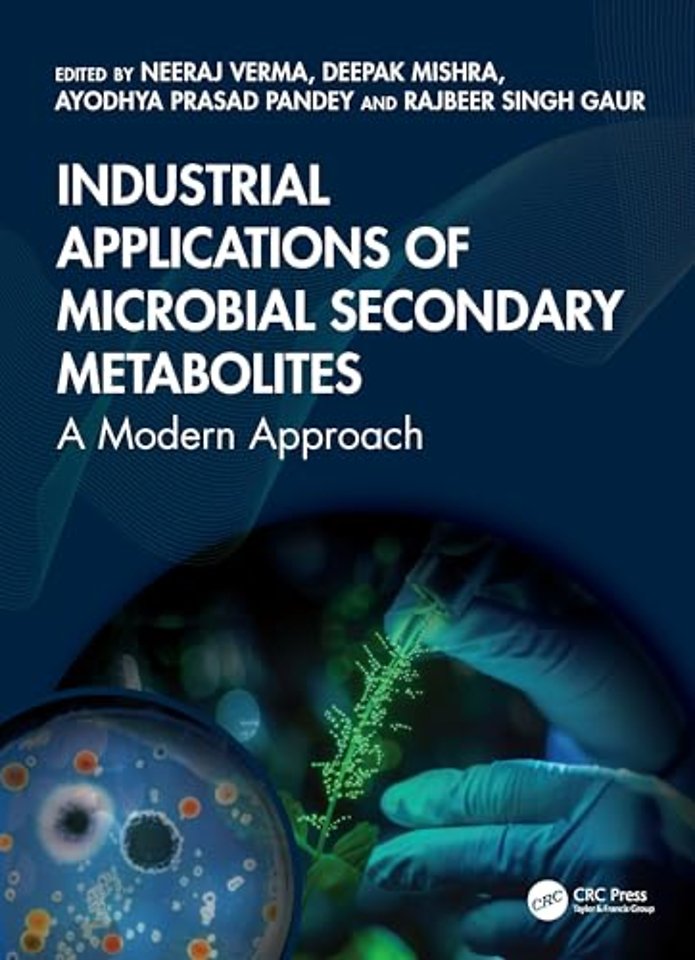
Industrial Applications of Microbial Secondary Metabolites
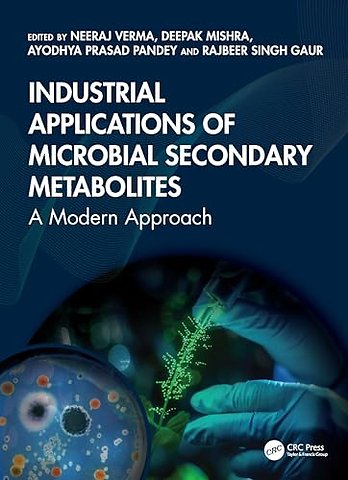

Industrial Applications of Microbial Secondary Metabolites
A Modern Approach
Samenvatting
This comprehensive volume presents the fascinating and diverse world of microbial secondary metabolites, exploring their biosynthesis, ecological roles, and wide-ranging applications in biotechnology, pharmacy, agriculture, and various other industries.